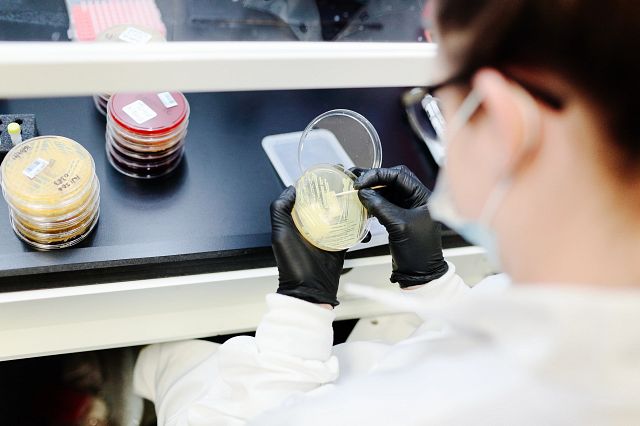
This webinar examines a real-world case study where inaccurate microbial identification methods led a company down an erroneous and costly investigation path.

An Accurate Identification Matters
When a microbial contamination event occurs, personal care and cosmetic product manufacturers must quickly identify the root cause to ensure timely production. Species-level identification may not be enough to establish root cause; strain typing can determine whether microorganisms originate from the same or different sources. To comply with Cosmetics Regulation (EC) 1223/2009 and guarantee product safety, reliable testing of raw materials and formulations is essential. Accugenix offers microbial analysis of cosmetic products, including strain typing, MALDI-TOF technology and DNA sequencing paired with comprehensive fungal and bacterial databases. Results are delivered in 5 days or less (including same-day service), enabling fast, confident decisions for routine monitoring and urgent investigations.
Webinar: The Hidden Costs of Microbial Misidentifications
This webinar examines a real-world case study where inaccurate microbial identification methods led a company down an erroneous and costly investigation path.
Watch the Webinar
Accugenix® Microbial ID Services for Effective Microbial Analysis of Cosmetic Products
AccuGENX-ID®
AccuGENX-ID works by comparing the DNA sequence of submitted samples to our validated library – the industry’s most up-to-date database for environmental isolates. Our expertise includes the ability to distinguish between very closely related microorganism groups to the species level, such as Burkholderia cepacia complex and many others.
Learn More
AccuPRO-ID®
The MALDI-TOF assay yields a unique protein spectral fingerprint that is then compared against the Accugenix database for bacterial, yeast, and filamentous fungi identification. Proteotypic IDs are a convenient solution, as it is more accurate and reproducible than phenotypic methods.
Learn More
AccuGENX-ST®
Our microbial analysis of cosmetic products go the extra mile with strain typing services that offer unparalleled accuracy you can rely on. When a contaminant is encountered, you can quickly pinpoint where you have seen that particular strain before, greatly reducing time and cost associated with investigations
Learn More
Next Generation Sequencing (NGS)
NGS for bacterial and fungal identification, a technology that enables high throughput, scalability, and novel applications. When investigating mixed species environments, it provides an understanding of microbial populations without the need for any culturing. NGS provides a deeper resolution of organism genes and variants at a level never before seen.
Learn More
MicroLearning Series
Expand your knowledge on microbial detection and identification with our MicroLearning video series. Watch at your own pace with bite-sized content presented by our experts.
Watch Now
Benefits of Accugenix Microbial Databases
The accuracy of an identification is dependent on the method used to generate and interpret the data as well as the library database. If the organism you are trying to ID isn’t in the library – you won't get an ID, or worse, you may get an incorrect ID and incorrect assessment of the risk. To combat this, our proprietary organism library:
- Is based on real industry samples currently being recovered in QC labs around the world.
- Contains 14,000+ unique bacterial and fungal species and being updated in real time.
- Contains more strains than any other commercial database and offers superior coverage of water organisms.
Take Complete Control of Your ID Data
Effective contamination control requires not only detecting contamination but also accurately identifying its source to understand facility microflora, guide cleaning and disinfection strategies, and pinpoint risk areas. A proactive contamination control strategy—supported by routine environmental monitoring and data trending as recommended by regulators—helps manufacturers mitigate issues quickly. The Accugenix® Customer Web Portal streamlines sample submission and review while offering customizable, 21 CFR Part 11–compliant tools for tracking, trending, and analyzing environmental isolates. All Accugenix® laboratories follow harmonized, validated processes and operate under ISO 17025 accreditation to ensure consistent, high quality microbial identification worldwide.
Explore the Accugenix® Customer Web Portal
eBook: Personal Care Product Testing with Rapid Microbiological Methods
This guide outlines how to implement rapid microbiological methods for home and personal care product testing by dismantling common misconceptions and unveiling a more streamlined approach.
Get the eBook